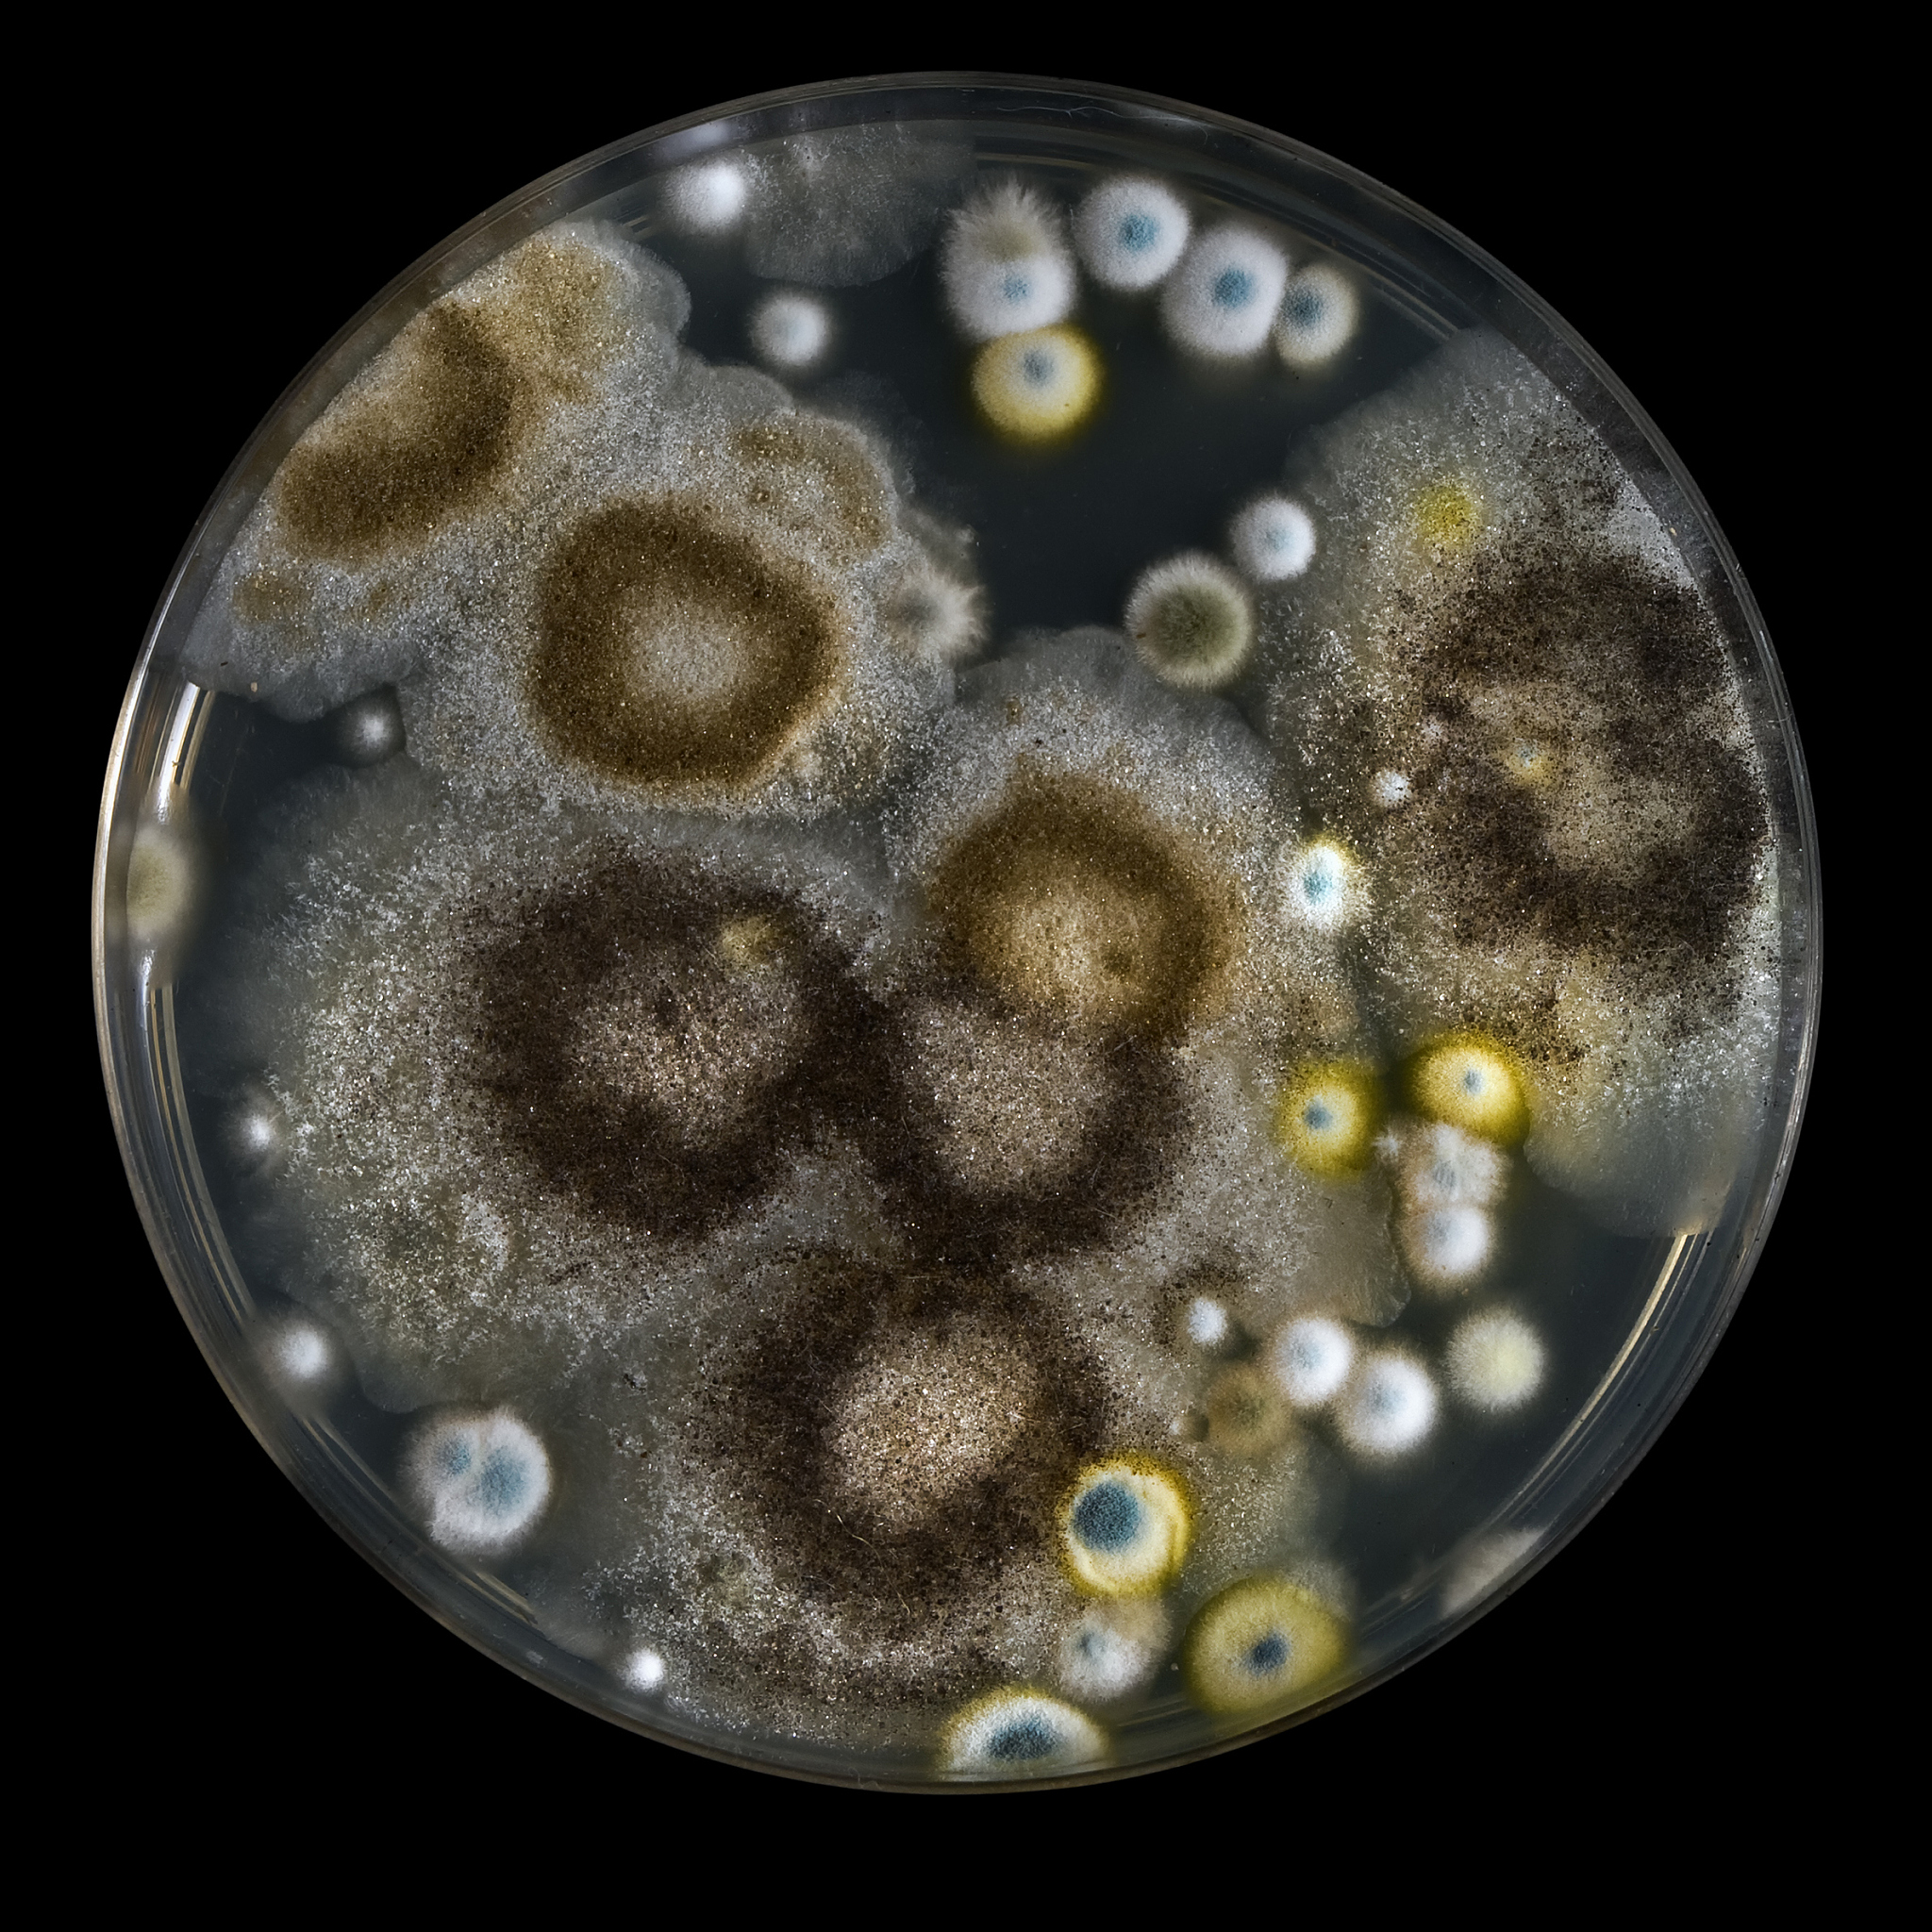
酵母微粒体提取方法：破菌步骤详解

酵母微粒体提取方法:破菌步骤详解
提取酵母微粒体时,可以采用以下步骤破菌:
-
培养酵母菌株:将所需酵母菌株接种在适当的培养基中,并在适当的条件下培养至适宜的生长阶段。
-
收获细胞:将培养的酵母细胞通过离心等方式收获,去除培养基和其他杂质。
-
洗涤细胞:用适当的洗涤缓冲液(如PBS缓冲液)洗涤酵母细胞,去除残留的培养基和其他污染物。
-
破碎细胞壁:使用适当的方法破碎酵母细胞壁,以释放细胞质中的微粒体。常用的破碎方法包括机械破碎、酶解和超声破碎等。
-
离心离取:将破碎后的细胞质进行离心,以去除细胞核、细胞膜和其他细胞碎片等杂质。
-
提取微粒体:将离心得到的沉淀进行溶解或抽提,以提取纯净的酵母微粒体。
-
进一步纯化:根据需要,可以采用进一步的纯化步骤,如离心、超速离心、层析等技术,以获得更纯净的酵母微粒体。
需要注意的是,提取酵母微粒体的具体步骤可能会因具体实验目的和所用方法的不同而有所差异,建议参考相关文献或专业实验方法进行操作。
原文地址: https://www.cveoy.top/t/topic/ph8Z 著作权归作者所有。请勿转载和采集!